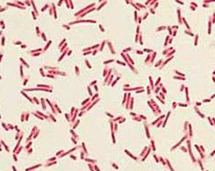

Eukaryotes and Prokaryotes
1/14
There's no tags or description
Looks like no tags are added yet.
Name | Mastery | Learn | Test | Matching | Spaced |
|---|
No study sessions yet.
15 Terms
prokaryote (Definition)
A unicellular organism that lacks a nucleus and membrane bound organelles
prokryote (Animated Picture)

eukaryote (Definition)
A cell that contains a nucleus and membrane-bound organelles
eukaryote (Animated Picture)

the cell is more organized and complex
eukaryote
examples of eukaryotic cells
plant and animal cells
prokaryotic cells are much __ in size then eukaryotic cells
smaller
these types of cells are always unicellular
prokaryotic (Unicellular or Multi?)
simple unorganized cell
prokaryotic
organelles that are shared by prokaryotic and eukaryotic cells
cell membrane
prokaryote (Circle Picture)

eukaryote (Plant Cell)

prokaryote
eukaryote (Animal Cell)

Complex and Multi Cellular
Eukaryotic